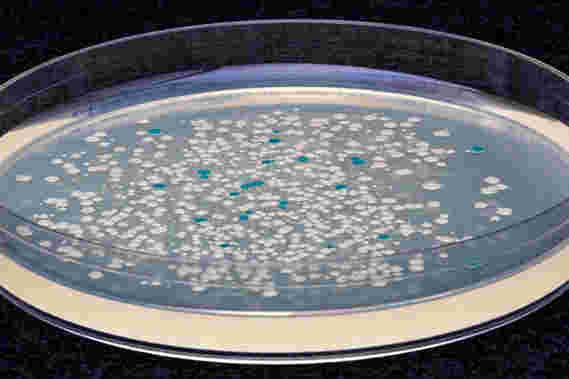

时间:2021-11-17 13:58:08来源:
在含有乳糖的培养基上生长时,添加ATC时活跃的工程化大肠杆菌菌落会变成蓝色,而添加ATC时没有融合的工程化大肠杆菌则保持白色。
威斯研究所(Wyss Institute)的科学家利用合成生物学技术发现,细菌在体内的反应与在皮氏培养皿中的反应截然不同-实际上完全相反,这表明我们目前对抗生素的某些假设可能是错误的。
细菌感染是美国住院患者的第一大死亡原因,并且抗生素耐药性细菌正在增加,每年导致成千上万的死亡。准确了解抗生素的作用方式对于开发替代治疗策略至关重要,既可以针对新的“超级细菌”,也可以使现有药物更有效地实现其目标。
“大多数临床医生的形象是,抗生素通过杀死活跃的细菌而起作用,而非脂解性细菌则是抵抗治疗并导致感染持续的细菌。我想知道这是否是真的–感染过程中黏附细菌的比例是否发生变化,抗生素如何影响这种变化?”威斯研究所和马萨诸塞州总医院的临床研究员劳拉·塞莫说,该研究的第一作者发表在8月31日的Cell Host&Microbe上。
她说:“合成生物学广泛用于工程改造细菌,以便它们产生有用的产物或诊断疾病,我们使用相同的方法来创建微生物学工具,该工具可以告诉我们细菌在体内的行为方式。”
某些人和她的同事使用了几年前在Wyss核心教职人员Pamela Silver的实验室中创建的转基因大肠杆菌菌株。细菌在其DNA中编码有一个遗传的“拨动开关”,当细菌暴露于称为脱水四环素(ATC)的化学物质中时,该开关便从“关闭”变为“开启”。当开关打开时,发生了遗传变化,使细菌能够消化糖乳糖,而那些保持断开状态的细菌则不能。该系统的关键是,只有在添加ATC时细菌正处于活动状态,才可以拨动拨动开关;即使存在ATC,非脂类细菌的开关也将保持关闭状态。因此,拨动开关会及时提供快照,以指示在ATC暴露时细菌是处于活动状态还是处于休眠状态。
细菌研究通常在体外进行,但感染发生在复杂的生物环境中,这与培养皿完全不同。为了评估他们体内的细菌,研究人员将一根小的塑料棒植入小鼠的腿中,并将其工程菌菌株接种到腿中,以模仿植入医疗设备和人工关节时人类常见的慢性细菌感染。然后,他们在整个感染过程中的不同时间向小鼠注射ATC,以将任何细菌细菌细胞中的拨动开关拨至“开”位置。
当他们从小鼠中提取细菌并使其在含有乳糖的特殊培养基上生长时,他们发现所有细菌在最初的24小时内都处于活跃状态,但是到第四天,这一比例下降到一半左右,其余时间保持不变细菌感染的数量表明,被细胞杀死的新细菌平衡了机体杀死的细菌数量。该结果与体外反应不同,在体外反应中,一旦所有细菌达到其环境的承载能力,它们就会停止沉淀。
接下来,科学家通过让细菌感染持续两周,然后给小鼠注射抗生素左氧氟沙星,测试了细菌对体内抗生素的反应。当他们分析提取的细菌时,他们发现,虽然小鼠中细菌的总数减少了,但活跃的存活细菌的比例实际上却增加了。这一结果与体外观察到的抗生素直接相反,后者杀死了更多的黏附细胞,而不是未染色的细胞。研究人员筛选了细菌菌落是否具有抗生素抗性,但没有发现任何证据表明细菌已经进化出能更好地耐受左氧氟沙星的杀伤作用,从而证实了抗生素仍然有效。
某些人说:“有几种可能的原因导致我们在抗生素存在下看到更多的定居细菌。”“我们发现最有可能的是,休眠细胞正在转变为活跃状态,以'填补当抗生素减少总细菌数量时出现的空白。正如我们的研究表明的那样,如果细菌在整个感染过程中继续活跃,它们应该对抗生素敏感。”
确实,研究人员能够用更高剂量的抗生素治愈感染,这表明,与传统的细菌感染假设相反,在这种慢性感染模型中,没有固定数量的休眠的耐抗生素细胞。
“如果抗生素不起作用,我们应该集中精力寻找将更多的抗生素递送到感染部位的方法,或者确定可能发挥作用的其他耐受机制,而不是假定是非pid虫细菌的堡垒。”通讯作者兼Wyss核心教员Jim Collins,他同时还是麻省理工学院的泰米尔医学工程与科学教授和生物工程学教授。
出版物:Laura K.某些,等人,“利用工程菌表征体内感染动力学和抗生素作用”,《细胞宿主与微生物》,2017年; doi:10.1016 / j.chom.2017.08.001
声明:文章仅代表原作者观点,不代表本站立场;如有侵权、违规,可直接反馈本站,我们将会作修改或删除处理。
图文推荐
2021-11-17 13:58:03
2021-11-17 12:58:03
2021-11-17 10:58:02
2021-11-17 09:58:03
2021-11-17 08:58:03
2021-11-16 19:58:02
热点排行
精彩文章
2021-11-17 13:58:05
2021-11-17 12:58:05
2021-11-17 11:58:04
2021-11-17 10:58:04
2021-11-17 09:58:05
2021-11-17 08:58:05
热门推荐